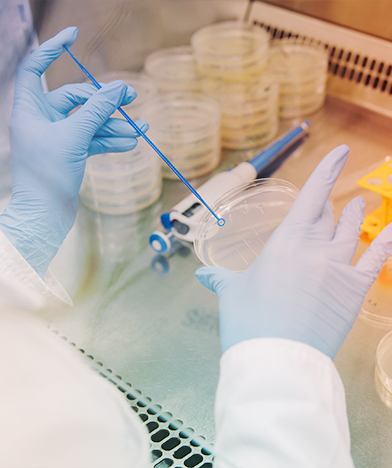

SENAI CETIQT - Centro de Tecnologia da Indústria Química e Têxtil

Metrologia
Os laboratórios de Metrologia do SENAI CETIQT oferecem serviços abrangentes de ensaios e testes em sete áreas especializadas, incluindo flamabilidade, calibração, microbiologia, química, toxicidade, colorimetria e ensaios físicos. A partir de uma infraestrutura moderna e uma equipe técnica qualificada, contribuímos para a garantia da qualidade, segurança e conformidade de produtos industriais, como materiais têxteis e instrumentos ópticos. Conheça os nossos laboratórios!
Os laboratórios do SENAI CETIQT, pertencentes a Coordenação de Serviços Metrológicos (CSM), possuem infraestrutura moderna e uma equipe técnica qualificada e experiente, que realizam ensaios mecânicos, químicos, microbiológicos, colorimétricos, de toxicidade e de flamabilidade em materiais têxteis e calibrações de instrumentos ópticos. Todos os serviços seguem a ABNT NBR ISO/IEC 17025:2017, com rastreabilidade nacional e internacional.
Em 1984, foi o primeiro laboratório da área têxtil acreditado junto à Coordenação Geral de Acreditação do Inmetro (Cgcre) sob o CRL nº 0005. Em 2001, obteve também a acreditação para o laboratório de Colorimetria (CAL nº 0172).
Hoje, os laboratórios da CSM realizam mais de 300 serviços metrológicos com mais de 70 ensaios acreditados junto a Cgcre, com rastreabilidade a laboratórios nacionais e internacionais (NPL, NRC, entre outros).
Conheça os nossos laboratórios!
Descubra a excelência da infraestrutura e equipe técnica dos laboratórios do SENAI CETIQT. Realizamos ensaios precisos e calibrações de instrumentos ópticos em total conformidade com normas nacionais e internacionais.
Pronto para dar vida ao seu projeto?
Nós também estamos! Compartilhe o seu objetivo e vamos transformá-lo em ação juntos. Estamos a um clique de distância. Vamos conversar!
Clientes satisfeitos
Nossos clientes falam por nós. Descubra como trabalhar conosco transformou seus desafios em oportunidades de crescimento.
Sua abordagem inovadora e ferramentas de última geração revolucionaram nossa produção. Agora, podemos desenvolver produtos de alta qualidade de maneira mais eficiente e sustentável. Obrigado por serem nossos parceiros na jornada da excelência têxtil.
Unidos pela transformação!
Conheça as organizações que já estão colhendo os frutos dessas parceria e aproveite oportunidade para alcançar resultados extraordinários também.